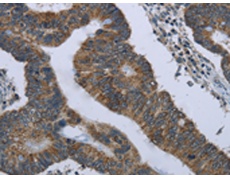
一抗

中文名稱:兔抗GYPC多克隆抗體
英文名稱: Anti-GYPC rabbit polyclonal antibody
別 名: GE; GPC; GPD; GYPD; CD236; PAS-2; CD236R; PAS-2
相關(guān)類別: 一抗
抗 原: GYPC
儲(chǔ) 存: 冷凍(-20℃)
宿 主: Rabbit
反應(yīng)種屬: Human
標(biāo)記物: Unconjugate
克隆類型: rabbit polyclonal
技術(shù)規(guī)格
|
Background: |
Glycophorin C (GYPC) is an integral membrane glycoprotein. It is a minor species carried by human erythrocytes, but plays an important role in regulating the mechanical stability of red cells. A number of glycophorin C mutations have been described. The Gerbich and Yus phenotypes are due to deletion of exon 3 and 2, respectively. The Webb and Duch antigens, also known as glycophorin D, result from single point mutations of the glycophorin C gene. The glycophorin C protein has very little homology with glycophorins A and B. Alternate splicing results in multiple transcript variants. |
|
Applications: |
ELISA, IHC |
|
Name of antibody: |
GYPC |
|
Immunogen: |
Fusion protein of human GYPC |
|
Full name: |
glycophorin C |
|
Synonyms: |
GE; GPC; GPD; GYPD; CD236; PAS-2; CD236R; PAS-2 |
|
SwissProt: |
P04921 |
|
ELISA Recommended dilution: |
2000-10000 |
|
IHC positive control: |
Human colon cancer and Human tonsil |
|
IHC Recommend dilution: |
100-300 |

 購(gòu)物車
購(gòu)物車 幫助
幫助
 021-54845833/15800441009
021-54845833/15800441009